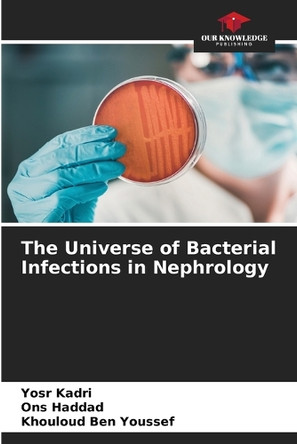
The Universe of Bacterial Infections in Nephrology by Yosr Kadri 9786208318475

Filter By
- Book
- Qty in Cart
- Quantity
- Price
- Subtotal
-

FC Gamma Receptor Activation in Microglia in Response to Cryptococcus by Xianyuan Song 9783639175745
RRP: £48.97Booksplease Price: £45.31Apologies but we at Booksplease don't have a full description for this book.Book InformationISBN 9783639175745Author Xianyuan SongFormat PaperbackImprint VDM VerlagPublisher VDM VerlagWeight(grams) 213g -

Advances in Microbiology: Volume I by Lucy Phillip 9781632390479
RRP: £99.99Booksplease Price: £90.60Apologies but we at Booksplease don't have a full description for this book.Book InformationISBN 9781632390479Author Lucy PhillipFormat HardbackImprint Callisto ReferencePublisher Callisto ReferenceWeight(grams) 798g -

Computing for Comparative Microbial Genomics: Bioinformatics for Microbiologists by David W. Ussery 9781849967631
Booksplease Price: £47.46Overview and Goals This book describes how to visualize and compare bacterial genomes. Sequencing technologies are becoming so inexpensive that soon going for a cup of coffee will be more expensive than sequencing a bacterial genome. Thus, there is a... -

Current Topics in Microbiology and Immunology / Ergebnisse der Mikrobiologie und Immunitatsforschung: Volume 72 by W. Arber 9783642461651
Booksplease Price: £93.11The study of streptococcal infections and their sequelae has in the last two decades yielded several important findings on the biological properties of cellular and extracellular products of group A streptococci. These findings have contributed to a... -

Fungal Diagnostics: Methods and Protocols by Louise O'Connor 9781493959808
Booksplease Price: £101.68Invasive fungal infections are a significant cause of morbidity and mortality. Over the past decade there has been a concerted effort to develop reliable methods for the detection of such infections. In Fungal Diagnostics: Methods and Protocols, expert... -

Soil Enzymes: Influence of Sugar Industry Effluents on Soil Enzyme Activities by Maddela Naga Raju 9783319426549
Booksplease Price: £47.16This book addresses issues arising from discharge of effluents from sugar industry on to surrounding land or into a water body such as physicochemical properties of soil, changes in the micro flora, quantification of soil enzyme activities as influenced... -

Iron Acquisition by the Genus Mycobacterium: History, Mechanisms, Role of Siderocalin, Anti-Tuberculosis Drug Development by B. Rowe Byers 9783319003023
Booksplease Price: £47.34Iron Acquisition by the Genus Mycobacterium summarizes the early evidence for the necessity of iron in mycobacteria and the discovery of the mycobacterial siderophores mycobactin, carboxymycobactin, and exochelin. The structural characterization of the... -

Hurdles for Phage Therapy (PT) to Become a Reality by Harald Brussow 9783039213917
RRP: £83.20Booksplease Price: £65.81Apologies but we at Booksplease don't have a full description for this book.Book InformationISBN 9783039213917Author Harald BrussowFormat PaperbackPage Count 484Imprint Mdpi AGPublisher Mdpi AGWeight(grams) 170g -

Metagenomics of the Human Body by Karen E. Nelson 9781489982407
Booksplease Price: £101.27The book brings a completely different perspective than available books by combining the information gained from the human genome with that derived from parallel metagenomic studies, and new results from investigating the effects of these microbes on the... -

Antioxidants in Animal Feed by Min Xue 9783036554716
RRP: £77.47Booksplease Price: £60.68Apologies but we at Booksplease don't have a full description for this book.Book InformationISBN 9783036554716Author Min XueFormat HardbackPage Count 316Imprint Mdpi AGPublisher Mdpi AGWeight(grams) 880g -

Calcium and Cellular Secretion by Ronald P. Rubin 9781468442199
Booksplease Price: £47.46Since the publication of my previous monograph in 1974, important progress has been made in the broad area of calcium research, partic- ularly as it pertains to secretory phenomena. The significant advance in methodology, while widening the scope of our... -

Studies on genetic relationships among locally cultivated Citrus varieties in Kerala employing matK and rbcL gene using PCR technique and RFLP markers by Jiby John Mathew 9783668480841
Booksplease Price: £55.84Apologies but we at Booksplease don't have a full description for this book.Book InformationISBN 9783668480841Author Jiby John MathewFormat PaperbackPage Count 64Imprint Grin PublishingPublisher Grin PublishingWeight(grams) 177g -

Current Topics in Microbiology and Immunology / Ergebnisse der Mikrobiologie und Immunitatsforschung: Volume 72 by W. Arber 9783642659102
Booksplease Price: £47.12Apologies but we at Booksplease don't have a full description for this book.Book InformationISBN 9783642659102Author W. ArberFormat PaperbackPage Count 126Imprint Springer-Verlag Berlin and Heidelberg GmbH & Co. KPublisher Springer-Verlag Berlin and... -

Biofuels Production – Sustainability and Advances in Microbial Bioresources by Ajar Nath Yadav 9783030539320
Booksplease Price: £93.12This book focuses on the different kinds of biofuels and biofuel resources. Biofuels represent a major type of renewable energy. As part of a larger bio-economy, they are closely linked to agriculture, forestry and manufacturing. Biofuels have the... -

The Proteasome - Ubiquitin Protein Degradation Pathway by Peter Zwickl 9783642639715
Booksplease Price: £92.83This volume gives an overview of pro tea some-mediated protein degradation and the regulatory role of the ubiquitin system in cellular proteolysis. The first chapter describes the molecular evolution of the proteasome and its associated activators, i. e... -

Stress Response Mechanisms in Fungi: Theoretical and Practical Aspects by Marek Skoneczny 9783030006822
Booksplease Price: £92.72This book covers both the molecular basics of fungal stress response strategies as well as biotechnological applications thereof. The complex regulatory mechanisms of stress response pathways are presented in a concise and well-readable manner. Also,... -

Rhizobacteria as bioinoculants by Ariel Mesquita 9786207660582
RRP: £37.00Booksplease Price: £34.75Apologies but we at Booksplease don't have a full description for this book.Book InformationISBN 9786207660582Author Ariel MesquitaFormat PaperbackPage Count 68Imprint Our Knowledge PublishingPublisher Our Knowledge PublishingWeight(grams)... -

Extremophiles by Rekadwad Bhagwan 9783659827860
RRP: £33.12Booksplease Price: £31.32Apologies but we at Booksplease don't have a full description for this book.Book InformationISBN 9783659827860Author Rekadwad BhagwanFormat PaperbackImprint LAP Lambert Academic PublishingPublisher LAP Lambert Academic PublishingWeight(grams) 113g -

Recognition in Microbe-Plant Symbiotic and Pathogenic Interactions by Ben Lugtenberg 9783642716546
Booksplease Price: £93.35This volume comprises the lectures of the speakers at the NATO Advanced Research Workshop held at the Congress Centre The Flevohof at Biddinghuizen, The Netherlands, May 11-16, 1986. The purpose of the workshop was to bring together experts in symbiosis,... -

Bacillus subtilis as a Model Organism to Study Basic Cell Processes by Imrich Barak 9783036537443
RRP: £49.60Booksplease Price: £39.61Apologies but we at Booksplease don't have a full description for this book.Book InformationISBN 9783036537443Author Imrich BarakFormat HardbackPage Count 214Imprint Mdpi AGPublisher Mdpi AGWeight(grams) 662g -

Current Topics in Microbiology and Immunology / Ergebnisse der Mikrobiologie und Immunitatsforschung: Volume 72 by W. Arber 9783642501142
Booksplease Price: £93.06This article is concerned with the use of viral models for the study of the mechanism of protein biosynthesis and its regulation. The scope is restricted mainly to general aspects of animal viral systems and how these systems may be used to approach the... -

Encyclopedia of Salmonella: Volume I (Integrated Studies) by Alan Klein 9781632392909
RRP: £94.95Booksplease Price: £86.16Apologies but we at Booksplease don't have a full description for this book.Book InformationISBN 9781632392909Author Alan KleinFormat HardbackImprint Callisto ReferencePublisher Callisto ReferenceWeight(grams) 608g -

Biodegradation of Some Pesticides by Soil Microorganisms by Hany Abdelrahman 9783639275063
RRP: £48.97Booksplease Price: £45.31Apologies but we at Booksplease don't have a full description for this book.Book InformationISBN 9783639275063Author Hany AbdelrahmanFormat PaperbackImprint VDM VerlagPublisher VDM VerlagWeight(grams) 204g -

Exposure to Microbiological Agents in Indoor and Occupational Environments by Carla Viegas 9783319871332
Booksplease Price: £114.86This book intends to provide information about detection and health effects due to bacteria, fungi and viruses in indoor environments. The book will cover also information about preventive and protective measures to avoid health-hazardous. Case studies... -
The Universe of Bacterial Infections in Nephrology by Yosr Kadri 9786208318475
RRP: £37.00Booksplease Price: £34.75Apologies but we at Booksplease don't have a full description for this book.Book InformationISBN 9786208318475Author Yosr KadriFormat PaperbackPage Count 60Imprint Our Knowledge PublishingPublisher Our Knowledge PublishingWeight(grams) 100g -

Biosurfactants of Lactic Acid Bacteria by Deepansh Sharma 9783319262130
Booksplease Price: £47.12This book provides an introduction to biosurfactants produced by lactic acid bacteria, presenting a detailed compilation of their functional properties and structural composition. Microbial surfactants, extensively known as surface-active agents, have... -

Microalgae as a Feedstock for Biofuels by Luisa Gouveia 9783642179969
Booksplease Price: £47.27This Brief provides a concise review of the potential use of microalgae for biofuel production. The following topics are highlighted: the advantages of microalgae over conventional biofuel-producing crops; technological processes for energy production... -

Sporotrichosis: New Developments and Future Prospects by Iracilda Zeppone Carlos 9783319372570
Booksplease Price: £92.77The book presents current affairs of Sporotrichosis as emergent disease with emphasis on the potential factors associated with genetic polymorphisms in Sporothrix complex. Constitutive and inducible factors play an essential role in the response of the... -

Bioinformatics Approaches for the Study of the Human Gut Microbiome by Casaburi Giorgio 9783639771466
RRP: £46.40Booksplease Price: £43.04Apologies but we at Booksplease don't have a full description for this book.Book InformationISBN 9783639771466Author Casaburi GiorgioFormat PaperbackImprint Edizioni Accademiche ItalianePublisher Edizioni Accademiche ItalianeWeight(grams) 209g -

Hydrocarbon and Lipid Microbiology Protocols: Single-Cell and Single-Molecule Methods by Terry J. McGenity 9783662491294
Booksplease Price: £93.12This Volume presents relevant single-cell and single-molecule approaches in the study of microbes producing and utilizing hydrocarbons and lipids. While generically applicable for all microorganisms, the approaches described are, wherever possible,... -

Biosafety in Microbiological and Biomedical Laboratories by United States. Dept. of Health and Human Services 9781907521607
Booksplease Price: £22.52Apologies but we at Booksplease don't have a full description for this book.Book InformationISBN 9781907521607Author United States. Dept. of Health and Human ServicesFormat PaperbackPage Count 438Imprint Books Express PublishingPublisher Books Express... -

Commercial Production Methods of Spirulina by Kowsalya Sasikumar 9783848427871
RRP: £40.67Booksplease Price: £37.98Apologies but we at Booksplease don't have a full description for this book.Book InformationISBN 9783848427871Author Kowsalya SasikumarFormat PaperbackImprint LAP Lambert Academic PublishingPublisher LAP Lambert Academic PublishingWeight(grams) 118g -

A Textbook of Immunology by H Vajiha Banu 9783848407101
RRP: £48.97Booksplease Price: £45.31Apologies but we at Booksplease don't have a full description for this book.Book InformationISBN 9783848407101Author H Vajiha BanuFormat PaperbackImprint LAP Lambert Academic PublishingPublisher LAP Lambert Academic PublishingWeight(grams) 245g -

Non-Saccharomyces Yeasts in Wine Production by Mateo Jose Juan 9783659490811
Booksplease Price: £27.21Apologies but we at Booksplease don't have a full description for this book.Book InformationISBN 9783659490811Author Mateo Jose JuanFormat PaperbackPage Count 76Imprint LAP Lambert Academic PublishingPublisher LAP Lambert Academic PublishingWeight(grams)... -

Medical Microbiology by S Rajan 9798224494965
RRP: £33.99Booksplease Price: £32.39Apologies but we at Booksplease don't have a full description for this book.Book InformationISBN 9798224494965Author S RajanFormat PaperbackPage Count 684Imprint Mjp PublishersPublisher Mjp PublishersWeight(grams) 898g -

Yeast Functional Genomics: Methods and Protocols by Frédéric Devaux 9781071622599
Booksplease Price: £115.16This second edition volume discusses the latest techniques and protocols used in the field that were not covered in the previous edition. The chapters in this book are organized into five parts. Part One looks at transcriptomic analyses and Part Two... -

Human Leukocyte HLA-B7 and HLA-B27 Antigen Typing Among Healthy Adults by Francis Millinga 9786139824908
RRP: £29.80Booksplease Price: £28.40Apologies but we at Booksplease don't have a full description for this book.Book InformationISBN 9786139824908Author Francis MillingaFormat PaperbackPage Count 52Imprint LAP Lambert Academic PublishingPublisher LAP Lambert Academic... -

Medical Bacteriology. Volume 13 by Hamidreza Honarmand 9786208224400
RRP: £99.00Booksplease Price: £89.73Apologies but we at Booksplease don't have a full description for this book.Book InformationISBN 9786208224400Author Hamidreza HonarmandFormat PaperbackPage Count 620Imprint LAP Lambert Academic PublishingPublisher LAP Lambert Academic... -

Current Topics in Microbiology and Immunology by W. Arber 9783642673436
Booksplease Price: £92.721.1 Classification of Togaviruses The family, Togaviridae, is composed of the alphaviruses, the flaviviruses, rubella (a rubivirus), and the pestiviruses (Fenner, 1976). Of these four genera, two (the alpha- and flaviviruses) are transmitted by... -

E Coli, Salmonella & Staphylococcus Aureus in Poultry Meat by Fernando Sudini 9783659720628
RRP: £41.42Booksplease Price: £38.64Apologies but we at Booksplease don't have a full description for this book.Book InformationISBN 9783659720628Author Fernando SudiniFormat PaperbackPage Count 92Imprint LAP Lambert Academic PublishingPublisher LAP Lambert Academic PublishingWeight(grams)...
